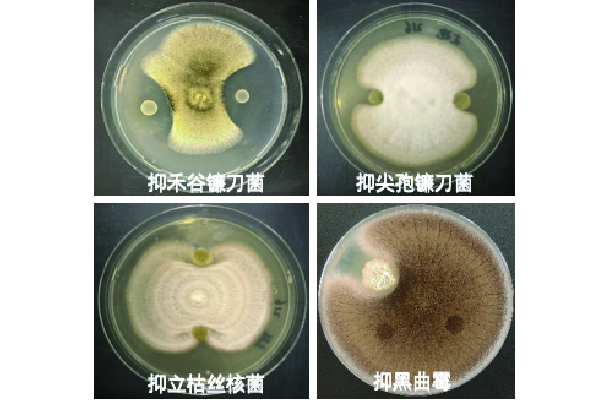

华益坤®
微生物菌剂
主要技术指标:有效活菌数≥50.0亿/mL
有效菌种:枯草芽孢杆菌、解淀粉芽孢杆菌、胶冻样类芽孢杆菌
剂型:液体
规格:1kg/瓶、20kg/桶
有效菌种:枯草芽孢杆菌、解淀粉芽孢杆菌、胶冻样类芽孢杆菌
剂型:液体
规格:1kg/瓶、20kg/桶
产品功效
富含百种抗菌肽,广谱强效抑菌,多重抗逆防病
高密度高活性,起效快速迅捷,功效持久稳定
激活土壤微生态,调节菌群环境,绿色健康无忧
适用作物及用法用量
| 作物 | 施用时期 | 用量 | 施用方式 |
|
大田作物 |
苗期、成熟期 |
每亩施用1kg-2kg,稀释100倍-200倍 |
冲施、滴灌、喷施 |
| 蔬菜作物 | 快速生长期 | 每亩施用1kg-5kg,稀释100倍-200倍 |
冲施、滴灌、喷施 |
1、本产品应放于通风、阴凉、干燥处储存,建议稀释后当日用完。
2、本产品应喷施在植株叶片表面。
3、本产品不得与杀菌剂产品同时混合使用。
科学实验
筛选具有抑制多种植物病害的生防菌株
示范应用

施用菌剂的棉花根系更加发达,抗病性增强,结铃数增加,产量增产7.5%





